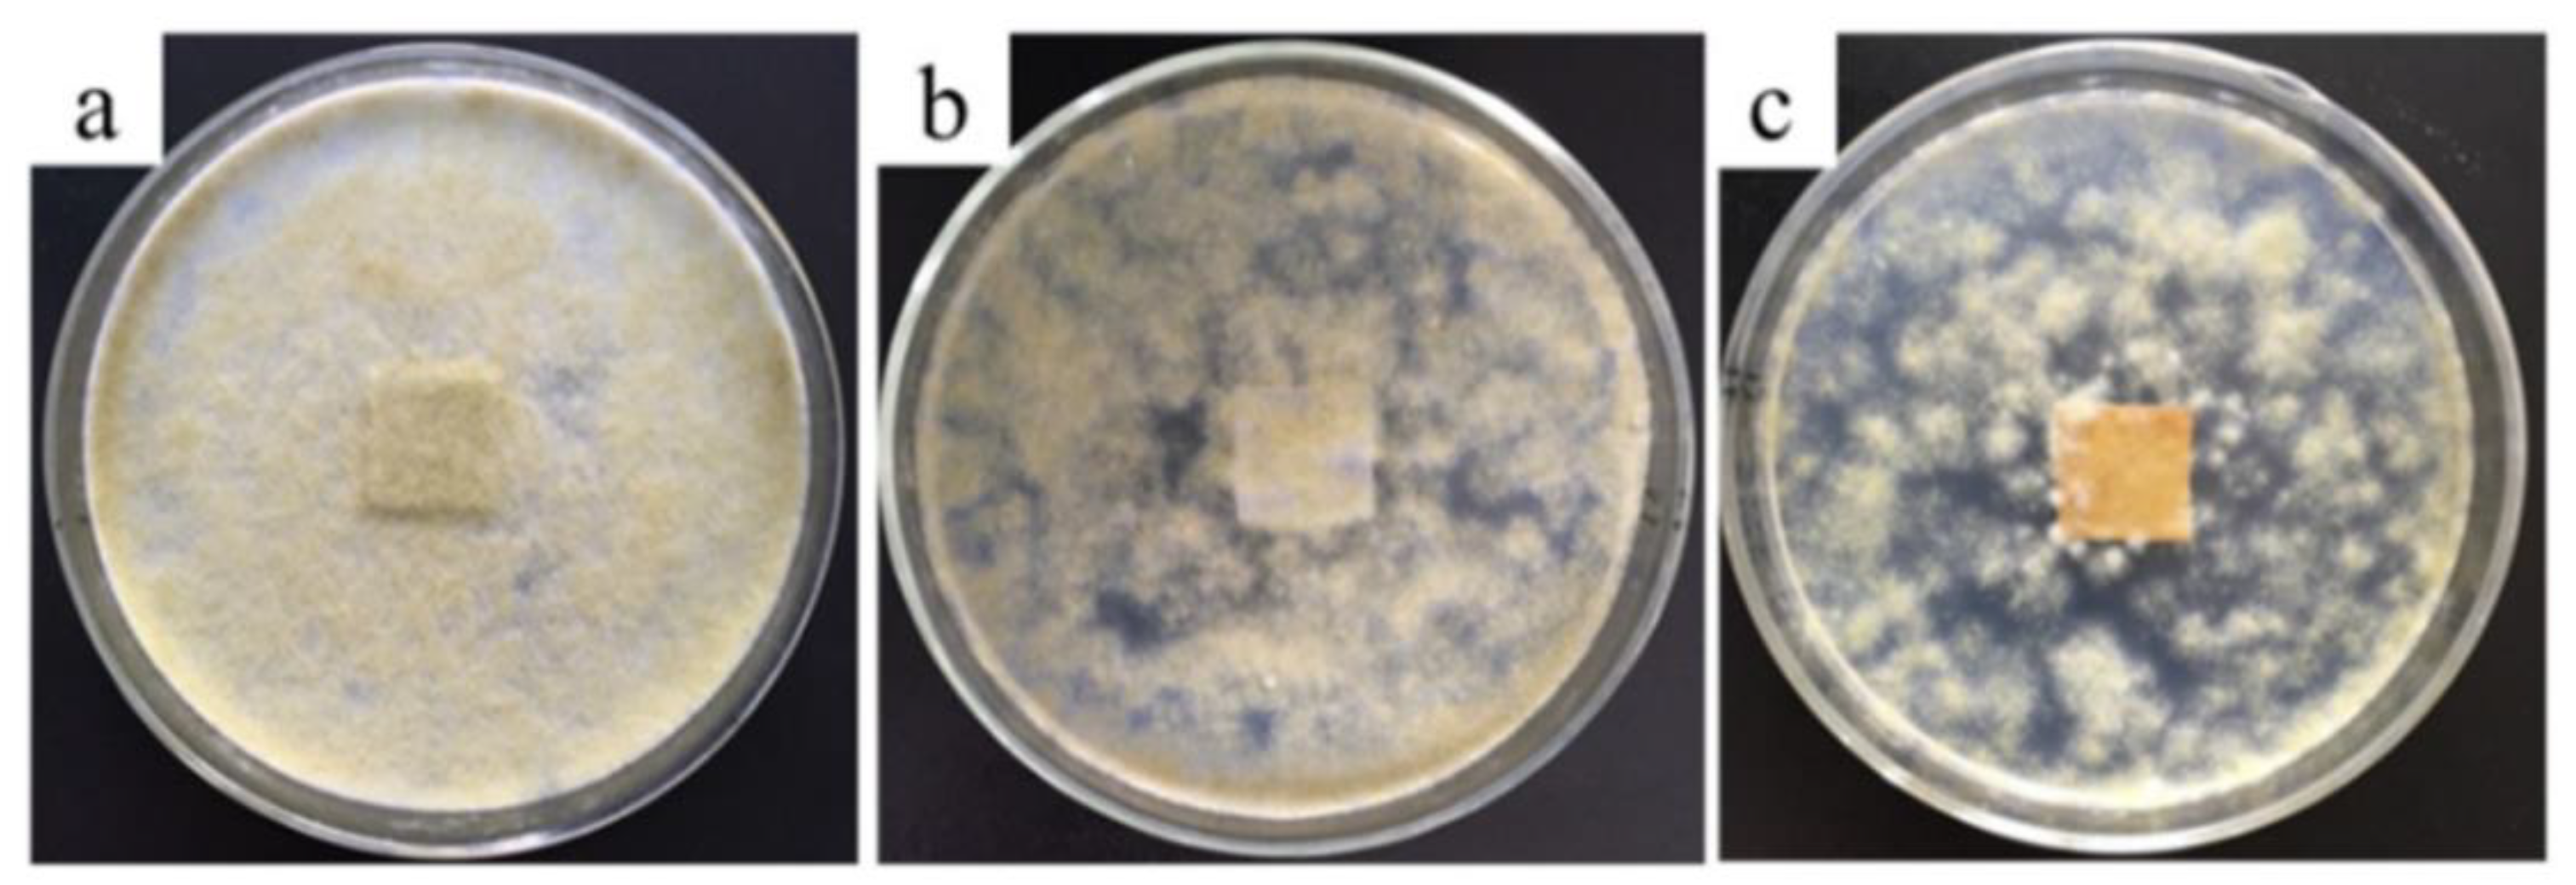
Coatings 09 00550 g006

Zinc Oxide for Functional Textile Coatings: Recent Advances
Abstract
1. Introduction
2. Characteristics of ZnO
3. Textile Functionalization
3.1. Photocatalytic Self-Cleaning Properties
3.2. Antimicrobial Properties
3.3. UV Protection
3.4. Thermal Insulation and Moisture Management
3.5. Flame Retardancy
3.6. Hydrophobicity
3.7. Electrical Conductivity
4. Conclusions and Future Perspectives
Funding
Conflicts of Interest
References
- Hackenberg, S.; Scherzed, A.; Technau, A.; Froelich, K.; Hagen, R.; Kleinsasser, N. Functional responses of human adipose tissue-derived mesenchymal stem cells to metal oxide nanoparticles in vitro. J. Biomed. Nanotechnol. 2013, 9, 86–95. [Google Scholar] [CrossRef] [PubMed]
- Kołodziejczak-Radzimska, A.; Jesionowski, T. Zinc oxide−from synthesis to application: A review. Materials 2014, 7, 2833–2881. [Google Scholar] [CrossRef] [PubMed]
- Becheri, A.; Dürr, M.; Nostro, P.L.; Baglioni, P. Synthesis and characterization of zinc oxide nanoparticles: Application to textiles as UV-absorbers. J. Nanopart. Res. 2008, 10, 679–689. [Google Scholar] [CrossRef]
- Parihar, V.; Raja, M.; Paulose, R. A brief review of structural, electrical and electrochemical properties of zinc oxide nanoparticles. Rev. Adv. Mater. Sci. 2018, 53, 119–130. [Google Scholar] [CrossRef]
- Samanta, A.K.; Bhattacharyya, R.; Jose, S.; Basu, G.; Chowdhury, R. Fire retardant finish of jute fabric with nano zinc oxide. Cellulose 2017, 24, 1143–1157. [Google Scholar] [CrossRef]
- Sheshama, M.; Khatri, H.; Suthar, M.; Basak, S.; Ali, W. Bulk vs. Nano ZnO: Influence of fire retardant behavior on sisal fibre yarn. Carbohydr. Polym. 2017, 175, 257–264. [Google Scholar] [CrossRef] [PubMed]
- Lam, Y.L.; Kan, C.W.; Yuen, C.W.M. Effect of zinc oxide on flame retardant finishing of plasma pre-treated cotton fabric. Cellulose 2011, 18, 151–165. [Google Scholar] [CrossRef]
- Cai, L.; Song, A.Y.; Li, W.; Hsu, P.C.; Lin, D.; Catrysse, P.B.; Liu, Y.; Peng, Y.; Chen, J.; Wang, H.; et al. Spectrally selective nanocomposite textile for outdoor personal cooling. Adv. Mater. 2018, 30, 1802152. [Google Scholar] [CrossRef]
- Chiu, W.T.; Chen, C.Y.; Chang, T.F.M.; Tahara, Y.; Hashimoto, T.; Kurosu, H.; Sone, M. Fabrication and photocatalytic performance of Au/ZnO layered structure on silk textile for flexible device applications. Electrochim. Acta 2017, 253, 39–46. [Google Scholar] [CrossRef]
- Wan, H.; Han, P.; Ge, S.; Li, F.; Zhang, S.; Li, H. Development zinc oxide–cotton fibers as anode materials for lithium-ion batteries. Int. J. Electrochem. Sci. 2018, 13, 4115–4122. [Google Scholar] [CrossRef]
- Karthik, S.; Siva, P.; Balu, K.S.; Suriyaprabha, R.; Rajendran, V.; Maaza, M. Acalypha indica–mediated green synthesis of ZnO nanostructures under differential thermal treatment: Effect on textile coating, hydrophobicity, UV resistance, and antibacterial activity. Adv. Powder Technol. 2017, 28, 3184–3194. [Google Scholar] [CrossRef]
- Pal, S.; Mondal, S.; Maity, J. Synthesis, characterization and photocatalytic properties of ZnO nanoparticles and cotton fabric modified with ZnO nanoparticles via in-situ hydrothermal coating technique: Dual response. Mater. Technol. 2018, 33, 884–891. [Google Scholar] [CrossRef]
- Thi, V.H.T.; Lee, B.K. Development of multifunctional self-cleaning and UV blocking cotton fabric with modification of photoactive ZnO coating via microwave method. J. Photochem. Photobiol. A Chem. 2017, 338, 13–22. [Google Scholar] [CrossRef]
- Ashraf, M.; Siyal, M.I.; Nazir, A.; Rehman, A. Single-step antimicrobial and moisture management finishing of PC fabric using ZnO nanoparticles. Autex Res. J. 2017, 17, 259–262. [Google Scholar] [CrossRef]
- Ramamurthy, P.; Chellamani, K.P.; Dhurai, B.; ThankaRajan, S.P.; Subramanian, B.; Santhini, E. Antimicrobial characteristics of pulsed laser deposited metal oxides on polypropylene hydroentangled nonwovens for medical textiles. Fibres Text. East. Eur. 2017, 112–119. [Google Scholar] [CrossRef]
- Amani, A.; Montazer, M.; Mahmoudirad, M. Synthesis of applicable hydrogel corn silk/ZnO nanocomposites on polyester fabric with antimicrobial properties and low cytotoxicity. Int. J. Biol. Macromol. 2019, 123, 1079–1090. [Google Scholar] [CrossRef]
- Sabir, S.; Arshad, M.; Chaudhari, S.K. Zinc oxide nanoparticles for revolutionizing agriculture: Synthesis and applications. Sci. World J. 2014, 2014, 925494. [Google Scholar] [CrossRef]
- Domingues, F.S.; Freitas, T.K.F.D.S.; de Almeida, C.A.; de Souza, R.P.; Ambrosio, E.; Palácio, S.M.; Garcia, J.C. Hydrogen peroxide-assisted photocatalytic degradation of textile wastewater using titanium dioxide and zinc oxide. Environ. Technol. 2017, 40, 1–10. [Google Scholar] [CrossRef]
- Savastenko, N.A.; Filatov, I.I.; Lyushkevich, V.A.; Chubrik, N.I.; Gabdullin, M.T.; Ramazanov, T.S.; Abdullin, H.A.; Kalkozova, V.A. Enhancement of ZnO-based photocatalyst activity by RF discharge-plasma treatment. J. Appl. Spectrosc. 2016, 83, 757–763. [Google Scholar] [CrossRef]
- Souza, R.P.; Ambrosio, E.; Souza, M.T.; Freitas, T.K.; Ferrari-Lima, A.M.; Garcia, J.C. Solar photocatalytic degradation of textile effluent with TiO2, ZnO, and Nb2O5 catalysts: Assessment of photocatalytic activity and mineralization. Environ. Sci. Pollut. Res. Int. 2017, 24, 12691–12699. [Google Scholar] [CrossRef]
- Mohd Hir, Z.; Abdullah, A.; Zainal, Z.; Lim, H. Photoactive hybrid film photocatalyst of polyethersulfone-ZnO for the degradation of methyl orange dye: Kinetic study and operational parameters. Catalysts 2017, 7, 16. [Google Scholar] [CrossRef]
- Sacco, O.; Matarangolo, M.; Vaiano, V.; Libralato, G.; Guida, M.; Lofrano, G.; Carotenuto, M. Crystal violet and toxicity removal by adsorption and simultaneous photocatalysis in a continuous flow micro-reactor. Sci. Total Environ. 2018, 644, 430–438. [Google Scholar] [CrossRef]
- Sacco, O.; Vaiano, V.; Matarangolo, M. ZnO supported on zeolite pellets as efficient catalytic system for the removal of caffeine by adsorption and photocatalysis. Sep. Purif. Technol. 2018, 193, 303–310. [Google Scholar] [CrossRef]
- Zhang, Y.; Ram, M.K.; Stefanakos, E.K.; Goswami, D.Y. Synthesis, characterization, and applications of ZnO nanowires. J. Nanomater. 2012, 2012, 20. [Google Scholar] [CrossRef]
- Kumar, S.G.; Rao, K.K. Zinc oxide based photocatalysis: Tailoring surface-bulk structure and related interfacial charge carrier dynamics for better environmental applications. RSC Adv. 2015, 5, 3306–3351. [Google Scholar] [CrossRef]
- Lee, K.M.; Lai, C.W.; Ngai, K.S.; Juan, J.C. Recent developments of zinc oxide based photocatalyst in water treatment technology: A review. Water Res. 2016, 88, 428–448. [Google Scholar] [CrossRef]
- Sushma, C.; Kumar, S.G. Advancements in the zinc oxide nanomaterials for efficient photocatalysis. Chem. Pap. 2017, 71, 2023–2042. [Google Scholar] [CrossRef]
- Ong, C.B.; Ng, L.Y.; Mohammad, A.W. A review of ZnO nanoparticles as solar photocatalysts: Synthesis, mechanisms and applications. Renew. Sustain. Energy Rev. 2018, 81, 536–551. [Google Scholar] [CrossRef]
- Mirzaei, H.; Darroudi, M. Zinc oxide nanoparticles: Biological synthesis and biomedical applications. Ceram. Int. 2017, 43, 907–914. [Google Scholar] [CrossRef]
- Ahmed, S.; Chaudhry, S.A.; Ikram, S. A review on biogenic synthesis of ZnO nanoparticles using plant extracts and microbes: A prospect towards green chemistry. J. Photochem. Photobiol. B Biol. 2017, 166, 272–284. [Google Scholar] [CrossRef]
- Umamaheswari, A.; Lakshmana Prabu, S.; Puratchikody, A. Biosynthesis of zinc oxide nanoparticle: A review on greener approach. MOJ Bioequivalence Bioavailab. 2018, 5, 151–154. [Google Scholar]
- Mishra, P.K.; Mishra, H.; Ekielski, A.; Talegaonkar, S.; Vaidya, B. Zinc oxide nanoparticles: A promising nanomaterial for biomedical applications. Drug Discov. Today 2017, 22, 1825–1834. [Google Scholar] [CrossRef]
- Jiang, J.; Pi, J.; Cai, J. The advancing of zinc oxide nanoparticles for biomedical applications. Bioinorg. Chem. Appl. 2018, 2018, 1062562. [Google Scholar] [CrossRef]
- Sirelkhatim, A.; Mahmud, S.; Seeni, A.; Kaus, N.H.M.; Ann, L.C.; Bakhori, S.K.M.; Hasan, H.; Mohamad, D. Review on zinc oxide nanoparticles: Antibacterial activity and toxicity mechanism. Nano-Micro Lett. 2015, 7, 219–242. [Google Scholar] [CrossRef]
- Kumar, R.; Umar, A.; Kumar, G.; Nalwa, H.S. Antimicrobial properties of ZnO nanomaterials: A review. Ceram. Int. 2017, 43, 3940–3961. [Google Scholar] [CrossRef]
- Siddiqi, K.S.; ur Rahman, A.; Husen, A. Properties of zinc oxide nanoparticles and their activity against microbes. Nanoscale Res. Lett. 2018, 13, 141. [Google Scholar] [CrossRef]
- Wang, J.; Zhao, J.; Sun, L.; Wang, X. A review on the application of photocatalytic materials on textiles. Text. Res. J. 2015, 85, 1104–1118. [Google Scholar] [CrossRef]
- Riaz, S.; Ashraf, M.; Hussain, T.; Hussain, M.T.; Rehman, A.; Javid, A.; Iqbal, K.; Basit, A.; Aziz, H. Functional finishing and coloration of textiles with nanomaterials. Color. Technol. 2018, 134, 327–346. [Google Scholar] [CrossRef]
- Zhao, S.W.; Guo, C.R.; Hu, Y.Z.; Guo, Y.R.; Pan, Q.J. The preparation and antibacterial activity of cellulose/ZnO composite: A review. Open Chem. 2018, 16, 9–20. [Google Scholar] [CrossRef]
- Tan, L.Y.; Sin, L.T.; Bee, S.T.; Ratnam, C.T.; Woo, K.K.; Tee, T.T.; Rahmat, A.R. A review of antimicrobial fabric containing nanostructures metal-based compound. J. Vinyl Addit. Technol. 2019, 25, E3–E27. [Google Scholar] [CrossRef]
- Janotti, A.; Van de Walle, C.G. Fundamentals of zinc oxide as a semiconductor. Rep. Prog. Phys. 2009, 72, 126501. [Google Scholar] [CrossRef]
- Ghayempour, S.; Montazer, M. Ultrasound irradiation based in-situ synthesis of star-like Tragacanth gum/zinc oxide nanoparticles on cotton fabric. Ultrason. Sonochem. 2017, 34, 458–465. [Google Scholar] [CrossRef] [PubMed]
- Manikandan, B.; Endo, T.; Kaneko, S.; Murali, K.R.; John, R. Properties of sol gel synthesized ZnO nanoparticles. J. Mater. Sci. Mater. Electron. 2018, 29, 9474–9485. [Google Scholar] [CrossRef]
- Al-Dhabi, N.; Valan Arasu, M. Environmentally-friendly green approach for the production of zinc oxide nanoparticles and their anti-fungal, ovicidal, and larvicidal properties. Nanomaterials 2018, 8, 500. [Google Scholar] [CrossRef] [PubMed]
- Singh, A.; Singh, N.B.; Afzal, S.; Singh, T.; Hussain, I. Zinc oxide nanoparticles: A review of their biological synthesis, antimicrobial activity, uptake, translocation and biotransformation in plants. J. Mater. Sci. 2018, 53, 185–201. [Google Scholar] [CrossRef]
- Sapkal, R.T.; Shinde, S.S.; Waghmode, T.R.; Govindwar, S.P.; Rajpure, K.Y.; Bhosale, C.H. Photo-corrosion inhibition and photoactivity enhancement with tailored zinc oxide thin films. J. Photochem. Photobiol. B Biol. 2012, 110, 15–21. [Google Scholar] [CrossRef] [PubMed]
- Wang, J.; Wang, Z.; Huang, B.; Ma, Y.; Liu, Y.; Qin, X.; Zhang, X.; Dai, Y. Oxygen vacancy induced band-gap narrowing and enhanced visible light photocatalytic activity of ZnO. ACS Appl. Mater. Interfaces 2012, 4, 4024–4030. [Google Scholar] [CrossRef] [PubMed]
- Wang, Y.; Shi, R.; Lin, J.; Zhu, Y. Enhancement of photocurrent and photocatalytic activity of ZnO hybridized with graphite-like C3N4. Energy Environ. Sci. 2011, 4, 2922–2929. [Google Scholar] [CrossRef]
- Razavi-Khosroshahi, H.; Edalati, K.; Wu, J.; Nakashima, Y.; Arita, M.; Ikoma, Y.; Sadakiyo, M.; Inagaki, Y.; Stayko, A.; Yamauchi, M.; et al. High-pressure zinc oxide phase as visible-light-active photocatalyst with narrow band gap. J. Mater. Chem. A 2017, 5, 20298–20303. [Google Scholar] [CrossRef]
- Ba-Abbad, M.M.; Kadhum, A.A.H.; Mohamad, A.B.; Takriff, M.S.; Sopian, K. The effect of process parameters on the size of ZnO nanoparticles synthesized via the sol–gel technique. J. Alloy. Compd. 2013, 550, 63–70. [Google Scholar] [CrossRef]
- Verbič, A.; Šala, M.; Gorjanc, M. The influence of in situ synthesis parameters on the formation of ZnO nanoparticles and the UPF value of cotton fabric. Tekstilec 2018, 61, 280–288. [Google Scholar] [CrossRef]
- Morkoç, H.; Özgür, Ü. Zinc Oxide: Fundamentals, Materials and Device Technology; John Wiley & Sons: Hoboken, NJ, USA, 2008. [Google Scholar]
- Wang, Z.L. Zinc oxide nanostructures: Growth, properties and applications. J. Phys. Condens. Matter 2004, 16, R829–R858. [Google Scholar] [CrossRef]
- Mclaren, A.; Valdes-Solis, T.; Li, G.; Tsang, S.C. Shape and size effects of ZnO nanocrystals on photocatalytic activity. J. Am. Chem. Soc. 2009, 131, 12540–12541. [Google Scholar] [CrossRef] [PubMed]
- Upadhyaya, H.; Shome, S.; Sarma, R.; Tewari, S.; Bhattacharya, M.K.; Panda, S.K. Green synthesis, characterization and antibacterial activity of ZnO nanoparticles. Am. J. Plant Sci. 2018, 9, 1279–1291. [Google Scholar] [CrossRef]
- Alves, T.E.P.; Kolodziej, C.; Burda, C.; Franco, A., Jr. Effect of particle shape and size on the morphology and optical properties of zinc oxide synthesized by the polyol method. Mater. Des. 2018, 146, 125–133. [Google Scholar] [CrossRef]
- Saito, N.; Watanabe, K.; Haneda, H.; Sakaguchi, I.; Shimanoe, K. Highly sensitive ethanol gas sensor using pyramid-shaped ZnO particles with (0001) basal plane. J. Phys. Chem. C 2018, 122, 7353–7360. [Google Scholar] [CrossRef]
- Carp, O.; Jurca, B.; Ene, R.; Somacescu, S.; Ianculescu, A. Biopolymer starch mediated synthetic route of multi-spheres and donut ZnO structures. Carbohydr. Polym. 2015, 115, 285–293. [Google Scholar] [CrossRef] [PubMed]
- Liang, J.; Liu, J.; Xie, Q.; Bai, S.; Yu, W.; Qian, Y. Hydrothermal growth and optical properties of doughnut-shaped ZnO microparticles. J. Phys. Chem. B 2005, 109, 9463–9467. [Google Scholar] [CrossRef]
- Chao, L.C.; Yang, S.H. Growth and Auger electron spectroscopy characterization of donut-shaped ZnO nanostructures. Appl. Surf. Sci. 2007, 253, 7162–7165. [Google Scholar] [CrossRef]
- Ghoshal, T.; Kar, S.; Chaudhuri, S. ZnO doughnuts: Controlled synthesis, growth mechanism, and optical properties. Cryst. Growth Des. 2007, 7, 136–141. [Google Scholar] [CrossRef]
- Zhao, D.; Zhou, Y.; Deng, Y.; Xiang, Y.; Zhang, Y.; Zhao, Z.; Zeng, D. A novel and reusable RGO/ZnO with nanosheets/microparticle composite photocatalysts for efficient pollutants degradation. ChemistrySelect 2018, 3, 8740–8747. [Google Scholar] [CrossRef]
- Gupta, A.; Srivastava, R. Zinc oxide nanoleaves: A scalable disperser-assisted sonochemical approach for synthesis and an antibacterial application. Ultrason. Sonochem. 2018, 41, 47–58. [Google Scholar] [CrossRef]
- Hughes, W.L.; Wang, Z.L. Formation of piezoelectric single-crystal nanorings and nanobows. J. Am. Chem. Soc. 2004, 126, 6703–6709. [Google Scholar] [CrossRef]
- Navaladian, S.; Viswanathan, B. Synthesis of different architectures like stars, multipods, ellipsoids and spikes of zinc oxide by surfactantless precipitation. J. Nanosci. Nanotechnol. 2011, 11, 10219–10226. [Google Scholar] [CrossRef]
- Kalpana, V.N.; Kataru, B.A.S.; Sravani, N.; Vigneshwari, T.; Panneerselvam, A.; Rajeswari, V.D. Biosynthesis of Zinc oxide nanoparticles using culture filtrates of Aspergillus niger: Antimicrobial textiles and dye degradation studies. OpenNano 2018, 3, 48–55. [Google Scholar] [CrossRef]
- Fouda, A.; Saad, E.L.; Salem, S.S.; Shaheen, T.I. In-vitro cytotoxicity, antibacterial, and UV protection properties of the biosynthesized Zinc oxide nanoparticles for medical textile applications. Microb. Pathog. 2018, 125, 252–261. [Google Scholar] [CrossRef]
- Das, M.P.; Rebecca, L.J. Evaluation of antibacterial efficacy of biogenic zinc oxide nanoparticles on cotton fabrics. Int. J. Pharm. Sci. Res. 2017, 9, 2553–2557. [Google Scholar]
- Mohamed, A.A.; Fouda, A.; Abdel-Rahman, M.A.; Hassan, S.E.D.; El-Gamal, M.S.; Salem, S.S.; Shaheen, T.I. Fungal strain impacts the shape, bioactivity and multifunctional properties of green synthesized zinc oxide nanoparticles. Biocatal. Agric. Biotechnol. 2019, 19, 101103. [Google Scholar] [CrossRef]
- Román, L.E.; Huachani, J.; Uribe, C.; Solís, J.; Gómez, M.; Costa, S.; Costa, S. Blocking erythemally weighted UV radiation using cotton fabrics functionalized with ZnO nanoparticles in situ. Appl. Surf. Sci. 2019, 469, 204–212. [Google Scholar] [CrossRef]
- Wang, W.; Liang, Y.; Yang, Z.; Zhang, W.; Wang, S. Construction of ultraviolet protection, thermal insulation, superhydrophobic and aromatic textile with Al-doped ZnO–embedded lemon microcapsule coatings. Text. Res. J. 2019. [Google Scholar] [CrossRef]
- Kar, T.R.; Samanta, A.K.; Sajid, M.; Kaware, R. UV protection and antimicrobial finish on cotton khadi fabric using a mixture of nanoparticles of zinc oxide and poly-hydroxy-amino methyl silicone. Text. Res. J. 2019, 89, 2260–2278. [Google Scholar] [CrossRef]
- Pandimurugan, R.; Thambidurai, S. UV protection and antibacterial properties of seaweed capped ZnO nanoparticles coated cotton fabrics. Int. J. Biol. Macromol. 2017, 105, 788–795. [Google Scholar] [CrossRef] [PubMed]
- Zhu, C.; Shi, J.; Xu, S.; Ishimori, M.; Sui, J.; Morikawa, H. Design and characterization of self-cleaning cotton fabrics exploiting zinc oxide nanoparticle-triggered photocatalytic degradation. Cellulose 2017, 24, 2657–2667. [Google Scholar] [CrossRef]
- Salat, M.; Petkova, P.; Hoyo, J.; Perelshtein, I.; Gedanken, A.; Tzanov, T. Durable antimicrobial cotton textiles coated sonochemically with ZnO nanoparticles embedded in an in-situ enzymatically generated bioadhesive. Carbohydr. Polym. 2018, 189, 198–203. [Google Scholar] [CrossRef] [PubMed]
- Primc, G.; Tomšič, B.; Vesel, A.; Mozetič, M.; Ražić, S.E.; Gorjanc, M. Biodegradability of oxygen-plasma treated cellulose textile functionalized with ZnO nanoparticles as antibacterial treatment. J. Phys. D Appl. Phys. 2016, 49, 324002. [Google Scholar] [CrossRef]
- Jazbec, K.; Šala, M.; Mozetič, M.; Vesel, A.; Gorjanc, M. Functionalization of cellulose fibres with oxygen plasma and ZnO nanoparticles for achieving UV protective properties. J. Nanomater. 2015, 16, 25. [Google Scholar] [CrossRef]
- Arputharaj, A.; Prasad, V.; Saxena, S.; Nadanathangam, V.; Shukla, S.R. Ionic liquid mediated application of nano zinc oxide on cotton fabric for multi-functional properties. J. Text. Inst. 2017, 108, 1189–1197. [Google Scholar] [CrossRef]
- Ghasemi, N.; Seyfi, J.; Asadollahzadeh, M.J. Imparting superhydrophobic and antibacterial properties onto the cotton fabrics: Synergistic effect of zinc oxide nanoparticles and octadecanethiol. Cellulose 2018, 25, 4211–4222. [Google Scholar] [CrossRef]
- Khan, M.Z.; Baheti, V.; Ashraf, M.; Hussain, T.; Ali, A.; Javid, A.; Rehman, A. Development of UV protective, superhydrophobic and antibacterial textiles using ZnO and TiO2 nanoparticles. Fibers Polym. 2018, 19, 1647–1654. [Google Scholar] [CrossRef]
- Seki, Y. Conductive cotton fabrics coated with Myristic acid/zinc oxide nanoparticles. Polym. Plast. Technol. 2018, 57, 766–774. [Google Scholar] [CrossRef]
- D’Água, R.B.; Branquinho, R.; Duarte, M.P.; Maurício, E.; Fernando, A.L.; Martins, R.; Fortunato, E. Efficient coverage of ZnO nanoparticles on cotton fibres for antibacterial finishing using a rapid and low cost in situ synthesis. New J. Chem. 2018, 42, 1052–1060. [Google Scholar] [CrossRef]
- Shaheen, T.I.; El-Naggar, M.E.; Abdelgawad, A.M.; Hebeish, A. Durable antibacterial and UV protections of in situ synthesized zinc oxide nanoparticles onto cotton fabrics. Int. J. Biol. Macromol. 2016, 83, 426–432. [Google Scholar] [CrossRef]
- Arputharaj, A.; Nadanathangam, V.; Shukla, S.R. A simple and efficient protocol to develop durable multifunctional property to cellulosic materials using in situ generated nano-ZnO. Cellulose 2017, 24, 3399–3410. [Google Scholar] [CrossRef]
- Souza, D.A.R.; Gusatti, M.; Ternus, R.Z.; Fiori, M.A.; Riella, H.G. In situ growth of ZnO nanostructures on cotton fabric by solochemical process for antibacterial purposes. J. Nanomater. 2018, 2018, 9082191. [Google Scholar] [CrossRef]
- El-Naggar, M.E.; Shaarawy, S.; Hebeish, A.A. Multifunctional properties of cotton fabrics coated with in situ synthesis of zinc oxide nanoparticles capped with date seed extract. Carbohydr. Polym. 2018, 181, 307–316. [Google Scholar] [CrossRef]
- Noorian, S.A.; Hemmatinejad, N.; Bashari, A. One-pot synthesis of Cu2O/ZnO nanoparticles at present of folic acid to improve UV-protective effect of cotton fabrics. Photochem. Photobiol. 2015, 91, 510–517. [Google Scholar] [CrossRef]
- Ran, J.; He, M.; Li, W.; Cheng, D.; Wang, X. Growing ZnO nanoparticles on polydopamine-templated cotton fabrics for durable antimicrobial activity and UV protection. Polymers 2018, 10, 495. [Google Scholar] [CrossRef]
- Veluswamy, P.; Sathiyamoorthy, S.; Khan, F.; Ghosh, A.; Abhijit, M.; Hayakawa, Y.; Ikeda, H. Incorporation of ZnO and their composite nanostructured material into a cotton fabric platform for wearable device applications. Carbohydr. Polym. 2017, 157, 1801–1808. [Google Scholar] [CrossRef]
- Subbiah, D.K.; Mani, G.K.; Babu, K.J.; Das, A.; Rayappan, J.B.B. Nanostructured ZnO on cotton fabrics—A novel flexible gas sensor & UV filter. J. Clean. Prod. 2018, 194, 372–382. [Google Scholar] [CrossRef]
- El-Nahhal, I.M.; Elmanama, A.A.; El Ashgar, N.M.; Amara, N.; Selmane, M.; Chehimi, M.M. Stabilization of nano-structured ZnO particles onto the surface of cotton fibers using different surfactants and their antimicrobial activity. Ultrason. Sonochem. 2017, 38, 478–487. [Google Scholar] [CrossRef]
- Timothy, R.; Arul Pragasam, A.J. Effect of weave structures and zinc oxide nanoparticles on the ultraviolet protection of cotton fabrics. Fibres Text. East. Eur. 2018, 1, 113–119. [Google Scholar] [CrossRef]
- Karttunen, A.J.; Sarnes, L.; Townsend, R.; Mikkonen, J.; Karppinen, M. Flexible thermoelectric ZnO–organic superlattices on cotton textile substrates by ALD/MLD. Adv. Electron. Mater. 2017, 3, 1600459. [Google Scholar] [CrossRef]
- Rastgoo, M.; Montazer, M.; Harifi, T.; Mahmoudi Rad, M. Dual metal oxide loaded cotton/polyester fabric with photo, bio and magnetic properties. J. Ind. Text. 2019. [Google Scholar] [CrossRef]
- Costa, S.; Ferreira, D.; Ferreira, A.; Vaz, F.; Fangueiro, R. Multifunctional flax fibres based on the combined effect of silver and zinc oxide (Ag/ZnO) nanostructures. Nanomaterials 2018, 8, 1069. [Google Scholar] [CrossRef]
- Samanta, A.K.; Roy, R.B.; Bagchi, A.; Chowdhuri, R. Statistical optimisation of nano-zinc oxide-based fire-protective finish on jute fabric. In Functional Textiles and Clothing; Springer: Singapore, 2019; pp. 167–191. [Google Scholar]
- Arfaoui, M.A.; Dolez, P.I.; Dubé, M.; David, É. Development and characterization of a hydrophobic treatment for jute fibres based on zinc oxide nanoparticles and a fatty acid. Appl. Surf. Sci. 2017, 397, 19–29. [Google Scholar] [CrossRef]
- Zhang, Z.; Chen, Y.; Guo, J. ZnO nanorods patterned-textile using a novel hydrothermal method for sandwich structured-piezoelectric nanogenerator for human energy harvesting. Phys. E 2019, 105, 212–218. [Google Scholar] [CrossRef]
- Fiedot-Toboła, M.; Ciesielska, M.; Maliszewska, I.; Rac-Rumijowska, O.; Suchorska-Woźniak, P.; Teterycz, H.; Bryjak, M. Deposition of zinc oxide on different polymer textiles and their antibacterial properties. Materials 2018, 11, 707. [Google Scholar] [CrossRef]
- Fiedot, M.; Maliszewska, I.; Rac-Rumijowska, O.; Suchorska-Woźniak, P.; Lewińska, A.; Teterycz, H. The relationship between the mechanism of zinc oxide crystallization and its antimicrobial properties for the surface modification of surgical meshes. Materials 2017, 10, 353. [Google Scholar] [CrossRef]
- Nourbakhsh, S.; Montazer, M.; Khandaghabadi, Z. Zinc oxide nano particles coating on polyester fabric functionalized through alkali treatment. J. Ind. Text. 2018, 47, 1006–1023. [Google Scholar] [CrossRef]
- Yuan, X.; Wei, Q.; Ke, H.; Huang, Z.; Chen, D. Structural color and photocatalytic property of polyester fabrics coated with Ag/ZnO composite films. Int. J. Cloth. Sci. Tech. 2019. [Google Scholar] [CrossRef]
- Ashraf, M.; Champagne, P.; Perwuelz, A.; Campagne, C.; Leriche, A. Photocatalytic solution discoloration and self-cleaning by polyester fabric functionalized with ZnO nanorods. J. Ind. Text. 2015, 44, 884–898. [Google Scholar] [CrossRef]
- Sudrajat, H.; Babel, S. A new, cost-effective solar photoactive system N-ZnO@polyester fabric for degradation of recalcitrant compound in a continuous flow reactor. Mater. Res. Bull. 2016, 83, 369–378. [Google Scholar] [CrossRef]
- Sudrajat, H. Superior photocatalytic activity of polyester fabrics coated with zinc oxide from waste hot dipping zinc. J. Clean. Prod. 2018, 172, 1722–1729. [Google Scholar] [CrossRef]
- Wang, M.; Zhang, M.; Pang, L.; Yang, C.; Zhang, Y.; Hu, J.; Wu, G. Fabrication of highly durable polysiloxane-zinc oxide (ZnO) coated polyethylene terephthalate (PET) fabric with improved ultraviolet resistance, hydrophobicity, and thermal resistance. J. Colloid Interface Sci. 2019, 537, 91–100. [Google Scholar] [CrossRef]
- Mirjalili, M.; Mohammadi, M.; Karimi, L. Effect of zinc oxide nanoparticles and sodium hydroxide on the self-cleaning and antibacterial properties of polyethylene terephthalate. Tekstilec 2017, 60, 269–274. [Google Scholar] [CrossRef]
- Pomerantz, N.L.; Anderson, E.E.; Dugan, N.P.; Hoffman, N.F.; Barton, H.F.; Lee, D.T.; Oldham, C.J.; Peterson, G.W.; Parsons, G.N. Air, water vapor, and aerosol transport through textiles with surface functional coatings of metal oxides and metal–organic frameworks. ACS Appl. Mater. Interfaces 2019, 11, 24683–24690. [Google Scholar] [CrossRef]
- Kim, J.H.; Joshi, M.K.; Lee, J.; Park, C.H.; Kim, C.S. Polydopamine-assisted immobilization of hierarchical zinc oxide nanostructures on electrospun nanofibrous membrane for photocatalysis and antimicrobial activity. J. Colloid Interface Sci. 2018, 513, 566–574. [Google Scholar] [CrossRef]
- Huang, J.; Yang, Y.; Yang, L.; Bu, Y.; Xia, T.; Gu, S.; Yang, H.; Ye, D.; Xu, W. Fabrication of multifunctional silk fabrics via one step in-situ synthesis of ZnO. Mater. Lett. 2019, 237, 149–151. [Google Scholar] [CrossRef]
- Mao, C.; Zhang, H.; Lu, Z. Flexible and wearable electronic silk fabrics for human physiological monitoring. Smart Mater. Struct. 2017, 26, 095033. [Google Scholar] [CrossRef]
- Saravanan, R.; Gracia, F.; Stephen, A. Basic principles, mechanism, and challenges of photocatalysis. In Nanocomposites for Visible Light-induced Photocatalysis; Khan, M.M., Pradhan, D., Sohn, Y., Eds.; Springer: Cham, Switzerland, 2017; pp. 19–40. [Google Scholar]
- Saad, S.R.; Mahmed, N.; Abdullah, M.M.A.B.; Sandu, A.V. Self-cleaning technology in fabric: A review. IOP Conf. Ser.: Mater. Sci. Eng. 2016, 133, 012028. [Google Scholar] [CrossRef]
- Wang, M.; Zhang, M.; Zhang, M.; Aizezi, M.; Zhang, Y.; Hu, J.; Wu, G. In-situ mineralized robust polysiloxane–Ag@ZnO on cotton for enhanced photocatalytic and antibacterial activities. Carbohydr. Polym. 2019, 217, 15–25. [Google Scholar] [CrossRef]
- Vigneshwaran, N.; Prasad, V.; Arputharaj, A.; Bharimalla, A.K.; Patil, P.G. Nano-zinc oxide: Prospects in the textile industry. In Nanomaterials in the Wet Processing of Textiles; Ul-Islam, S., Butola, B.S., Eds.; John Wiley & Sons: Hoboken, NJ, USA, 2018; Volume 1, pp. 113–134. [Google Scholar]
- Bedia, J.; Muelas-Ramos, V.; Peñas-Garzón, M.; Gómez-Avilés, A.; Rodríguez, J.; Belver, C. A review on the synthesis and characterization of metal organic frameworks for photocatalytic water purification. Catalysts 2019, 9, 52. [Google Scholar] [CrossRef]
- Mohammad, A.; Kapoor, K.; Mobin, S.M. Improved photocatalytic degradation of organic dyes by ZnO-nanoflowers. ChemistrySelect 2016, 1, 3483–3490. [Google Scholar] [CrossRef]
- Kumbhakar, P.; Pramanik, A.; Biswas, S.; Kole, A.K.; Sarkar, R.; Kumbhakar, P. In-situ synthesis of rGO-ZnO nanocomposite for demonstration of sunlight driven enhanced photocatalytic and self-cleaning of organic dyes and tea stains of cotton fabrics. J. Hazard. Mater. 2018, 360, 193–203. [Google Scholar] [CrossRef]
- Han, Y.; Obendorf, S.K. Reactivity and reusability of immobilized zinc oxide nanoparticles in fibers on methyl parathion decontamination. Text. Res. J. 2016, 86, 339–349. [Google Scholar] [CrossRef]
- Allen, J.A.; Murugesan, D.; Viswanathan, C. Circumferential growth of zinc oxide nanostructure anchored over carbon fabric and its photocatalytic performance towards p-nitrophenol. Superlattices Microstruct. 2019, 125, 159–167. [Google Scholar] [CrossRef]
- Joe, A.; Park, S.H.; Shim, K.D.; Kim, D.J.; Jhee, K.H.; Lee, H.W.; Heo, C.H.; Kim, H.M.; Jang, E.S. Antibacterial mechanism of ZnO nanoparticles under dark conditions. J. Ind. Eng. Chem. 2017, 45, 430–439. [Google Scholar] [CrossRef]
- Křížová, H.; Tuček, V.; Neoralová, J.; Wiener, J. Buffering and antibacterial properties of cotton canvas with dolomite/ZnO-styrene-acrylic complex coating and their comparison with properties after the accelerated aging. Tekstilec 2017, 60, 275–282. [Google Scholar] [CrossRef]
- Khalid, A.; Khan, R.; Ul-Islam, M.; Khan, T.; Wahid, F. Bacterial cellulose-zinc oxide nanocomposites as a novel dressing system for burn wounds. Carbohydr. Polym. 2017, 164, 214–221. [Google Scholar] [CrossRef]
- da Silva, M.G.; de Barros, M.A.S.; de Almeida, R.T.R.; Pilau, E.J.; Pinto, E.; Soares, G.; Santos, J.G. Cleaner production of antimicrobial and anti-UV cotton materials through dyeing with eucalyptus leaves extract. J. Clean. Prod. 2018, 199, 807–816. [Google Scholar] [CrossRef]
- Pulit-Prociak, J.; Chwastowski, J.; Kucharski, A.; Banach, M. Functionalization of textiles with silver and zinc oxide nanoparticles. Appl. Surf. Sci. 2016, 385, 543–553. [Google Scholar] [CrossRef]
- Gao, D.; Li, Y.; Lyu, B.; Lyu, L.; Chen, S.; Ma, J. Construction of durable antibacterial and anti-mildew cotton fabric based on P (DMDAAC-AGE)/Ag/ZnO composites. Carbohydr. Polym. 2019, 204, 161–169. [Google Scholar] [CrossRef]
- Hassabo, A.G.; El-Naggar, M.E.; Mohamed, A.L.; Hebeish, A.A. Development of multifunctional modified cotton fabric with tri-component nanoparticles of silver, copper and zinc oxide. Carbohydr. Polym. 2019, 210, 144–156. [Google Scholar] [CrossRef]
- Holt, B.A.; Gregory, S.A.; Sulchek, T.; Yee, S.; Losego, M.D. Aqueous zinc compounds as residual antimicrobial agents for textiles. ACS Appl. Mater. Interfaces 2018, 10, 7709–7716. [Google Scholar] [CrossRef]
- Fakoori, E.; Karami, H. Preparation and characterization of ZnO-PP nanocomposite fibers and non-woven fabrics. J. Text. Inst. 2018, 109, 1152–1158. [Google Scholar] [CrossRef]
- Rezaei, F.; Maleknia, L.; Valipour, P.; Chizari Fard, G. Improvement properties of nylon fabric by corona pre-treatment and nano coating. J. Text. Inst. 2016, 107, 1223–1231. [Google Scholar] [CrossRef]
- Chen, P.; Wang, H.; He, M.; Chen, B.; Yang, B.; Hu, B. Size-dependent cytotoxicity study of ZnO nanoparticles in HepG2 cells. Ecotoxicol. Environ. Saf. 2019, 171, 337–346. [Google Scholar] [CrossRef]
- Reddy, A.R.N.; Srividya, L. Evaluation of in vitro cytotoxicity of zinc oxide (ZnO) nanoparticles using human cell lines. J. Toxicol. Risk Assess. 2018, 4. [Google Scholar] [CrossRef]
- Rakhshaei, R.; Namazi, H.; Hamishehkar, H.; Kafil, H.S.; Salehi, R. In situ synthesized chitosan–gelatin/ZnO nanocomposite scaffold with drug delivery properties: Higher antibacterial and lower cytotoxicity effects. J. Appl. Polym. Sci. 2019, 136, 47590. [Google Scholar] [CrossRef]
- De Andrade Vieira, J.E.; de Oliveira Ferreira, R.; dos Reis Sampaio, D.M.; da Costa Araújo, A.P.; Malafaia, G. An insight on the mutagenicity and cytotoxicity of zinc oxide nanoparticles in Gallus gallus domesticus (Phasianidae). Chemosphere 2019, 231, 10–19. [Google Scholar] [CrossRef]
- Alebeid, O.K.; Zhao, T. Review on: Developing UV protection for cotton fabric. J. Text. Int. 2017, 108, 2027–2039. [Google Scholar] [CrossRef]
- AS/NZS 4399:2017 Sun Protective Clothing–Evaluation and Classification; Australian/New Zealand Standard: Sydney, Australia/Wellington, New Zealand, 2017.
- BS EN 13758-2:2003 Textiles. Solar UV Protective Properties. Classification and Marking of Apparel; European Standardization Committee: Brussels, Belgium, 2003.
- Morshed, M.N.; Azad, S.A.; Deb, H.; Islam, A.; Shen, X. Eco-friendly UV blocking finishes extracted from amaranthus viridis and solanum nigrum. Tekstilec 2018, 61. [Google Scholar] [CrossRef]
- Dal, V.; Şimşek, R.; Hes, L.; Akçagün, E.; Yilmaz, A. Investigation of thermal comfort properties of zinc oxide coated woven cotton fabric. J. Text. Int. 2017, 108, 337–340. [Google Scholar] [CrossRef]
- Dong, Y.; Thomas, N.L.; Lu, X. Electrospun dual-layer mats with covalently bonded ZnO nanoparticles for moisture wicking and antibacterial textiles. Mater. Des. 2017, 134, 54–63. [Google Scholar] [CrossRef]
- Alongi, J. Update on Flame Retardant Textiles; Smithers Rapra: Shrewsbury, UK, 2013. [Google Scholar]
- Wang, Y.W.; Shen, R.; Wang, Q.; Vasquez, Y. ZnO microstructures as flame-retardant coatings on cotton fabrics. ACS Omega 2018, 3, 6330–6338. [Google Scholar] [CrossRef]
- Rimbu, C.; Vrinceanu, N.; Broasca, G.; Farima, D.; Ciocoiu, M.; Campagne, C.; Suchea, M.; Nistor, A. Zinc oxide application in the textile industry: Surface tailoring and water barrier attributes as parameters with direct implication in comfort performance. Text. Res. J. 2013, 83, 2142–2151. [Google Scholar] [CrossRef]
- El-Hady, M.A.; Farouk, A.; Sharaf, S. Flame retardancy and UV protection of cotton based fabrics using nano ZnO and polycarboxylic acids. Carbohydr. Polym. 2013, 92, 400–406. [Google Scholar] [CrossRef]
- Ashraf, M.; Campagne, C.; Perwuelz, A.; Champagne, P.; Leriche, A.; Courtois, C. Development of superhydrophilic and superhydrophobic polyester fabric by growing zinc oxide nanorods. J. Colloid Interface Sci. 2013, 394, 545–553. [Google Scholar] [CrossRef]
- Song, J. Nanowires for smart textiles. In Smart Textiles: Wearable Nanotechnology; Yilmaz, N.D., Ed.; John Wiley & Sons: Hoboken, NJ, USA, 2018; pp. 127–177. [Google Scholar]
- Pu, X.; Hu, W.; Wang, Z.L. Nanogenerators for smart textiles. In Smart Textiles: Wearable Nanotechnology; Yilmaz, N.D., Ed.; John Wiley & Sons: Hoboken, NJ, USA, 2018; pp. 177–211. [Google Scholar]
- Seung, W.; Gupta, M.K.; Lee, K.Y.; Shin, K.S.; Lee, J.H.; Kim, T.Y.; Kim, S.; Lin, J.; Kim, J.H.; Kim, S.W. Nanopatterned textile-based wearable triboelectric nanogenerator. ACS Nano 2015, 9, 3501–3509. [Google Scholar] [CrossRef]
- Comini, E. Metal oxide nanowire chemical sensors: Innovation and quality of life. Mater. Today 2016, 19, 559–567. [Google Scholar] [CrossRef]
- Lee, K.S.; Shim, J.; Park, M.; Kim, H.Y.; Son, D.I. Transparent nanofiber textiles with intercalated ZnO@graphene QD LEDs for wearable electronics. Compos. Part B Eng. 2017, 130, 70–75. [Google Scholar] [CrossRef]
- Samuel, E.; Joshi, B.; Kim, M.W.; Kim, Y.I.; Swihart, M.T.; Yoon, S.S. Hierarchical zeolitic imidazolate framework-derived manganese-doped zinc oxide decorated carbon nanofiber electrodes for high performance flexible supercapacitors. Chem. Eng. J. 2019, 371, 657–665. [Google Scholar] [CrossRef]

| Textile Substrate | Synthesis Process | Shape of Particles/Structures | Size (a) of Particles/Structures | Application Method | Additional Treatment | Functionality | Ref. |
|---|---|---|---|---|---|---|---|
| Cotton | biosynthesis | spherical | 53−69 nm | pad-dry-cure | acrylic binder in the functionalization process | antimicrobial activity, photocatalytic degradation | [66] |
| biosynthesis | spherical | 10−45 nm | pad-dry-cure | no additional treatment | antibacterial activity, UV protection | [67] | |
| biosynthesis | spherical, rod-like | 30–80 nm, L: 100 nm, D: 5 nm | dip-coating | no additional treatment | antibacterial activity | [68] | |
| biosynthesis | hexagonal, rod-like | 10–42 nm, 8–38 nm | pad-dry-cure | no additional treatment | UV protection, antimicrobial activity | [69] | |
| green synthesis | spherical, irregular | 39.34 nm, 43.63 nm | pad-dry-cure | chitosan in the functionalization process | hydrophobicity, UV resistance, antibacterial activity | [11] | |
| precipitation | rods, sheets, flake-like, flower-like | not specified | dip-coating + microwave | no additional treatment | UV protection, photocatalytic self-cleaning | [13] | |
| precipitation | star-like | 0.5–1 µm | dip-coating | no additional treatment | UV protection | [70] | |
| precipitation | not specified | not specified | interfacial polymerization into microcapsules, pad-dry application | tetraethoxysilane and hexadecyltrimethoxysilane after-treatment | UV protection, thermal insulation, superhydrophobicity | [71] | |
| co-precipitation | hexagonal | 47.2 nm | pad-dry-cure | poly-hydroxy-amino methyl silicone binder in the functionalization process | UV protection, antimicrobial activity | [72] | |
| chemical precipitation | hexagonal | 24–28 nm | pad-dry-cure | NaOH after-treatment | UV protection, antimicrobial activity | [73] | |
| commercially available ZnO (not specified) | dip-pad-dry-cure | no additional treatment | photocatalytic degradation (Self-cleaning) | [74] | |||
| commercially available ZnO (not specified) | sonochemical coating | crosslinking agent (galic acid) in the functionalization process | antimicrobial activity | [75] | |||
| commercially available ZnO (not specified) | pad-dry | inductively coupled (RF) plasma pretreatment | antibacterial activity | [76] | |||
| commercially available ZnO (not specified) | pad-dry-cure | inductively coupled (RF) plasma pretreatment | UV protection | [77] | |||
| commercially available ZnO (not specified) | dip-coating | 1-butyl 3-methyl imidazolium chloride in the functionalization process | antibacterial activity, UV protection | [78] | |||
| commercially available ZnO (not specified) | dip-coating | octadecanethiol in the functionalization process or as an after-treatment | superhydrophobic, antibacterial activity | [79] | |||
| commercially available ZnO (not specified) | pad-dry-cure | organic/inorganic binder, repellent chemical in the functionalization process | UV protection, superhydrophobic, antibacterial activity | [80] | |||
| commercially available ZnO (not specified) | dip-coating | myristic acid in the functionalization process | electrical conductivity | [81] | |||
| hydrothermal | Hexagonal | 56 nm | dip-coating | fluoro-surfactant as stabilizer in the synthesis process | photocatalytic degradation | [12] | |
| in situ | star-like | 55–70 nm | dip-coating + sonication | Tragacanth gum in the functionalization process | photocatalytic degradation | [42] | |
| in situ | layers, spherical | not specified | in situ dip-coating | no additional treatment | UV protection | [51] | |
| in situ | spherical, elliptical | 37 nm | in situ sol-gel | no additional treatment | antibacterial activity | [82] | |
| in situ | not specified | 198.5 nm, 359 nm, 2520 nm | in situ dip-coating | hexamethyltriethylenetetramine in the functionalization process | antibacterial activity, UV protection | [83] | |
| in situ | Hexagonal | 35 nm | pad-dry-cure | no additional treatment | antibacterial activity, UV protection | [84] | |
| in situ | rod-like, spherical, plate-like | not specified | in situ sol-gel | no additional treatment | antibacterial activity | [85] | |
| in situ | Spherical | 97 nm | pad-dry-cure | NaOH pretreatment | antibacterial activity, UV protection | [86] | |
| in situ | nanoparticles, nanorods | 48−62 nm | in situ dip-coating | Cu2O, folic acid | UV protection | [87] | |
| solvothermal | rod-like | 1.76 ± 0.12 µm | dip-coating | polydopamine template as a pretreatment, hexamethyenetetraamine in the functionalization process | antimicrobial activity, UV protection | [88] | |
| solvothermal | rod-like | not specified | dip-coating | hexamethylenetetramine in the functionalization process | UV protection, electrical conductivity | [89] | |
| sol-gel | hexagonal | 18 nm, 19 nm | sputter seed layer deposition and sol-gel | NaOH pretreatment, hexamethylenetetramine in the functionalization process | UV protection, electrical conductivity | [90] | |
| ultrasonic | flake-like, flower-like, sheets, hexagonal | not specified | dip-coating + ultrasonic irradiation | sodium dodecyl sulfate as a pretreatment, different surfactants in the functionalization process | antimicrobial activity | [91] | |
| ultrasonic | needle-like, bramble-like | not specified | ultrasonic irradiation | sodium dodecyl sulfate as a pretreatment | electrical conductivity | [10] | |
| not specified | not specified | 50 nm | pad-dry-cure | acrylic binder in the functionalization process | UV protection | [92] | |
| not specified | not specified | not specified | atomic layer deposition/molecular layer deposition | pretreatment with Al2O3 seed layer deposition, hydroquinone in the synthesis process | electrical conductivity | [93] | |
| Cotton/ polyester | in situ sonosynthesis | semi-hexagonal nanosheets, cobblestone-like nanoparticles | 56 nm, 20 nm | in situ dip-coating + ultrasonic irradiation | Fe3O4, cetyltrimethylammonium bromide dispersing agent in the synthesis process | self-cleaning, antimicrobial activity | [94] |
| Flax | in situ | spherical, platelets | 58.3–223.9 nm, 600–684.2 nm | in situ dip-coating | deposition of Ag NPs as pretreatment | antibacterial activity, hydrophobicity, UV resistance | [95] |
| Jute | co-precipitation | not specified | 38–60 nm, 30–500 nm | pad-dry | potassium methyl siliconate in the functionalization process | fire retardancy | [5] |
| co-precipitation | rod-like | 38–60 nm | pad-dry-cure | hydroxymethyl amino siliconate binder in the functionalization process | fire retardancy | [96] | |
| Jute | solvothermal | rod-like | L: 2.5 µm, D: 140 ± 44 nm | dip-coating (seeding, growth) | hexamethylenetetramine in the functionalization process | hydrophobicity | [97] |
| Polyamide | hydrothermal in the presence of hexamethylen-etetramine | rod-like | not specified | dip-coating (seeding, growth) | screen printing of Ag as a pretreatment | electrical conductivity | [98] |
| Polyamide, polyester, polypropylene | not specified | microrods | L: 3.9± 0.4 µm, D: 252 ± 5 nm; L: 5.6 ± 0.2 µm, D: 389 ± 8 nm; L: 4.1 ± 0.6 µm, D: 313 ± 2 nm | hydrothermal deposition | hexamethylenetetramine in the functionalization process | antibacterial activity | [99] |
| Polyester | chemical bath deposition | rod-like | L: 1 µm, D: 450 nm | chemical bath deposition | hexamethylenetetramine in the functionalization process | antimicrobial activity | [100] |
| commercially available ZnO (not specified) | dip-coating | NaOH pretreatment or in the functionalization process | self-cleaning, antibacterial activity | [101] | |||
| 99.99% zinc target | RF megatron sputtering | deposition of Ag film using DC megratron sputtering before ZnO | photocatalytic degradation | [102] | |||
| hydrothermal | rod-like | L: 1 µm, D: 50 nm | seed layer deposition | plasma pretreatment, hexamethylenetetramine in the functionalization process | photocatalytic degradation, self-cleaning | [103] | |
| Mechanochemical | not specified | 30−60 nm | dip-coating + shaking | NaOH and UVC irradiation pretreatment | photocatalytic degradation | [104] | |
| sol-gel | irregular | ~40 nm | dip-coating + shaking | no additional treatment | photocatalytic degradation | [105] | |
| sol-gel in situ mineralization | wurzite | not specified | sol-gel in situ mineralization | radiation induced graft polymerization of c-methacryloxypropyl trimethoxysilane in the pretreatment process | UV resistance, hydrophobicity, thermal resistance | [106] | |
| Solvothermal | spherical | 34.12 nm | dip-coating | cetyltrimethylammonium bromide, urea and corn silk in the functionalization process | antimicrobial activity | [16] | |
| Ultrasonic | spherical | 52.6 nm | dip-coating + ultrasonic irradiation | no additional treatment | photocatalytic self-cleaning, antibacterial activity | [107] | |
| not specified | not specified | not specified | atomic layer deposition | cupric nitrate trihydrate, dimethylformamide, 1,3,5-benzene-tricarboxylic acid, anhydrous ethanol in the synthesis process | photocatalytic degradation | [108] | |
| Polyester/ cotton | sol-gel | not specified | 50, 130, 260, 380, 650 nm | pad-dry-cure | no additional treatment | antimicrobial activity, moisture management | [14] |
| Polypropylene, cotton | commercially available ZnO (not specified) | pulsed laser deposition | RF plasma pretreatment | antimicrobial activity | [15] | ||
| Polyurethane | Hydrothermal | nanoneedles | L: 2−3 µm, D: 30 nm | dip-coating | polydopamine pretreatment | photocatalytic degradation, antimicrobial activity | [109] |
| Silk | in situ | rod-like | L: 0.9−13 µm, D: 70−160 nm | in situ pad-dry | after-treatment with n-octadecenethiol | UV protection, superhydrophobicity | [110] |
| in situ | nanorod arrays | D: 100−200 nm | electro-deposition | no additional treatment | electrical conductivity | [111] | |
| in situ | tower-like nanowires | not specified | cathodic deposition | Au-metallization as a pretreatment | electrical conductivity | [9] | |
| Sisal | precipitation | not specified | not specified | dip-coating | butane tetracarboxylic acid in the functionalization process | fire retardancy | [6] |
© 2019 by the authors. Licensee MDPI, Basel, Switzerland. This article is an open access article distributed under the terms and conditions of the Creative Commons Attribution (CC BY) license (http://creativecommons.org/licenses/by/4.0/).
Share and Cite
Verbič, A.; Gorjanc, M.; Simončič, B. Zinc Oxide for Functional Textile Coatings: Recent Advances. Coatings 2019, 9, 550. https://doi.org/10.3390/coatings9090550
Verbič A, Gorjanc M, Simončič B. Zinc Oxide for Functional Textile Coatings: Recent Advances. Coatings. 2019; 9(9):550. https://doi.org/10.3390/coatings9090550
Chicago/Turabian StyleVerbič, Anja, Marija Gorjanc, and Barbara Simončič. 2019. "Zinc Oxide for Functional Textile Coatings: Recent Advances" Coatings 9, no. 9: 550. https://doi.org/10.3390/coatings9090550
APA StyleVerbič, A., Gorjanc, M., & Simončič, B. (2019). Zinc Oxide for Functional Textile Coatings: Recent Advances. Coatings, 9(9), 550. https://doi.org/10.3390/coatings9090550







